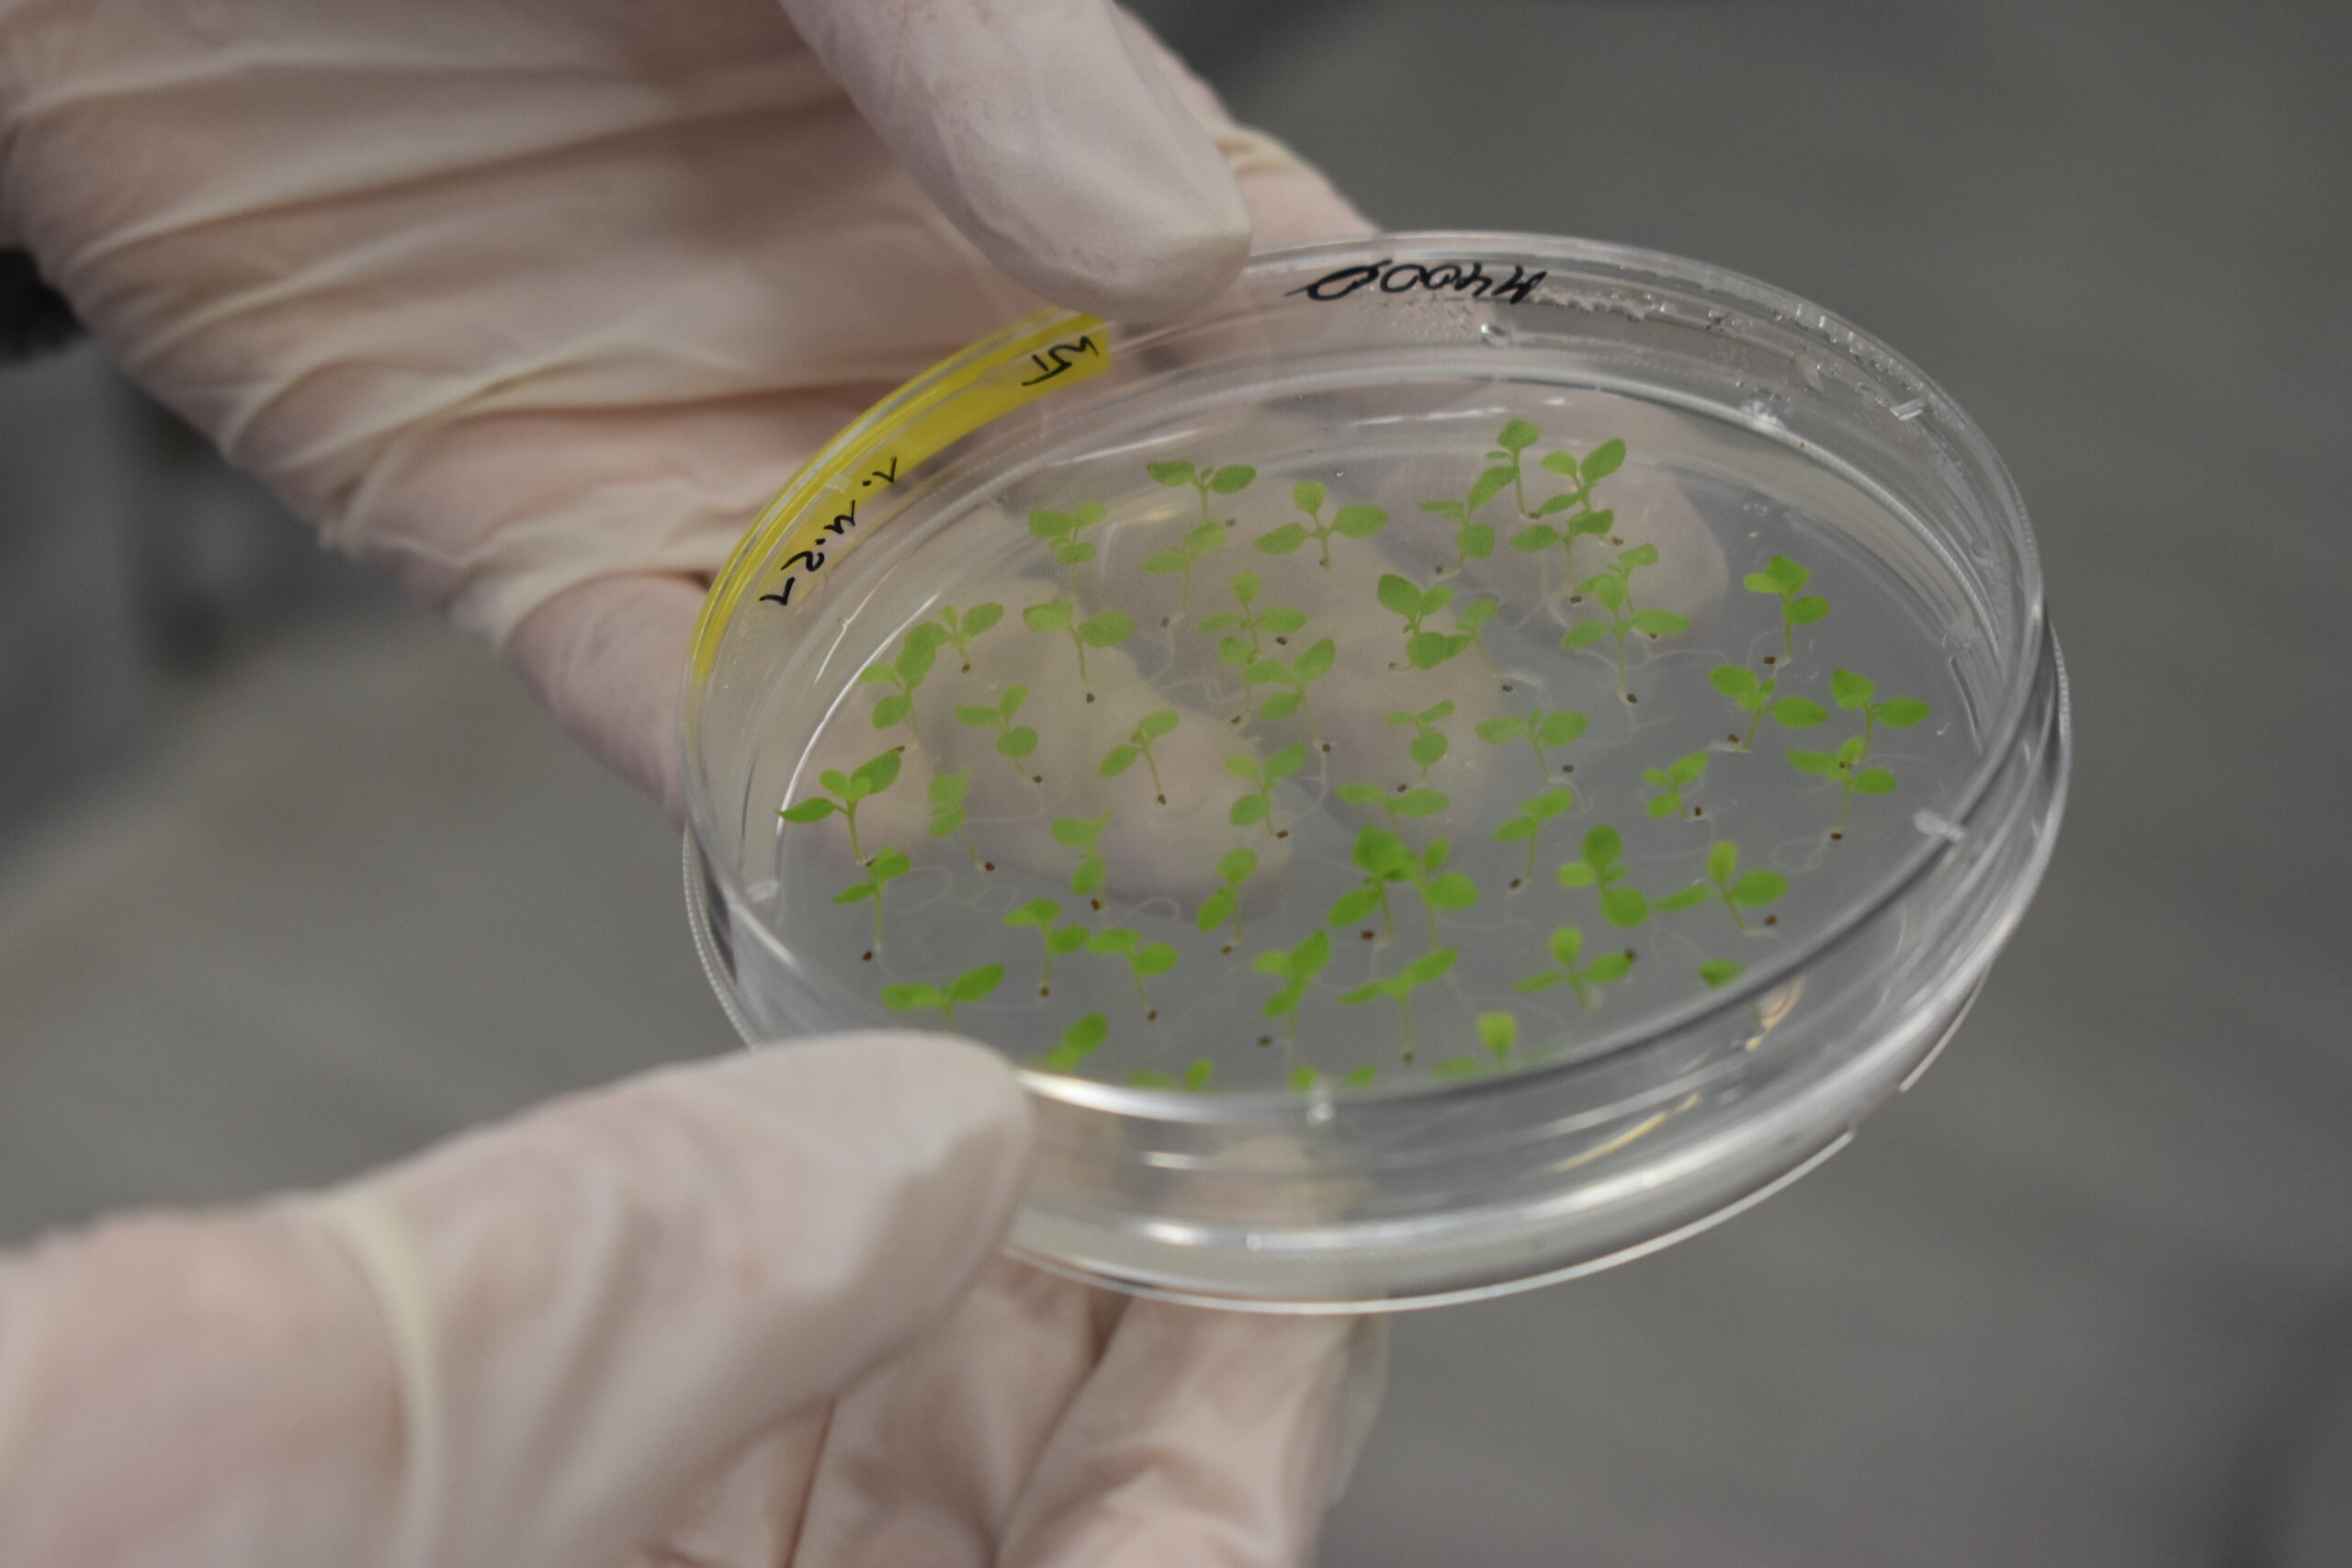

„Wovon träumst du in Halle?“ tumult im Kiosk
hr. fleischer - Kiosk am Reileck Händelstr. 1a, Halle (Saale)tumult im Kiosk geht in die zweite Runde: im September bespielt das Projekt tumult für und mit junge(n) Menschen der Stadt Halle (Saale) den Kunst- und Projektraum Kiosk am Reileck. […]